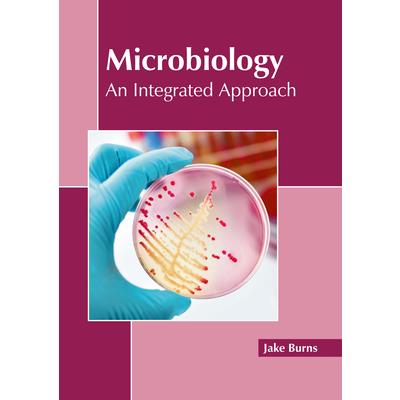
Microbiology: An Integrated Approach

Advances in Lipid Metabolism
This edited volume is a collection of reviewed and relevant research chapters concerning developments within the field of lipid metabolism. It includes scholarly contributions from experts in the field that cover such topics as roles of lipids in cancer, analytical tools for lipid assessment in biological assays, plant lipid metabolism, the effect of nanoparticles on lipid peroxidation in plants, and fatty acid compositions in fermented fish products. This book provides a thorough overview of the latest research efforts by international authors on lipid metabolism, and opens new possible research paths for further novel developments.
Evolution and Adaptation
Evolution and Adaptation, is many of the old classic books which have been considered important throughout the human history. They are now extremely scarce and very expensive antique. So that this work is never forgotten we republish these books in high quality, using the original text and artwork so that they can be preserved for the present and future generations. This whole book has been reformatted, retyped and designed. These books are not made of scanned copies of their original work and hence the text is clear and readable.
Fungi for Human Health
1. Preface2. Foreword3. Introduction4. Occurrence and distribution5. Traditional uses6. Fungi as food7. Fungi in medicine(i) Antidiabetic mushrooms(ii) Mushrooms as antioxidants(iii) Mushrooms against cancer(iv) Mushrooms as antimicrobial agents(v) Anti-inflammatory effects(vi) Other medicinal uses8. Mycochemicals composition of fungi9. Conclusion10. Outlook and future perspectives
Let's Read About Reptiles and Amphibians
This work has been selected by scholars as being culturally important and is part of the knowledge base of civilization as we know it.This work is in the public domain in the United States of America, and possibly other nations. Within the United States, you may freely copy and distribute this work, as no entity (individual or corporate) has a copyright on the body of the work.Scholars believe, and we concur, that this work is important enough to be preserved, reproduced, and made generally available to the public. To ensure a quality reading experience, this work has been proofread and republished using a format that seamlessly blends the original graphical elements with text in an easy-to-read typeface.We appreciate your support of the preservation process, and thank you for being an important part of keeping this knowledge alive and relevant.
The Colors of Genes
This essay deals with an opinion propounded by some academics and satisfactorily or resignedly accepted by the silent majority, an opinion according to which Africans and their descendants are intellectually inferior to peoples of other descents, particularly to Europeans or Asians. This opinion derives from a biased interpretation of the situation of sub-Saharan Africa and its diaspora during the last four centuries, a situation of submission to peoples technologically more equipped. To cite descent is to say heredity and genes. Proponents of the innate inferiority of Africans have used biological arguments to support their thesis. This essay presents counter-arguments to the thesis, drawing on the lessons of modern genetics. It begins with a survey of the notion of heredity in African traditions and demonstrates that Africans empirically knew that biological traits are transmissible and how to avoid transmitting deleterious ones. The essay goes on to describe how, in the course of the last two centuries, science has elucidated the laws of this transmission, has identified the germs that ensure it, has unraveled the molecule that embodies it: DNA which makes up genes. We are Homo sapiens and the products of our genes. We are surely newcomers in the long history of the Universe, the Earth, and Life. Our DNA, which delights in variations and diversity, carry the marks of our origins and our peregrinations throughout the planet. Molecular biology has unveiled these marks: they have revealed that we are all Afro-descendants; that our DNA variations are evenly distributed among us all, making us different between individuals, but not between ancestries; that, genetically speaking, 'races' do not exist, the traits that differentiate ancestries being mere superficial adaptations to the di-verse ecologies that housed them.It follows that our intelligence as Homo sapiens (a product of our genes) varies among individuals, but not among ancestries. Any contrary opinion is a denial of biology. It is an ideological choice born out of narcissistic view of oneself, a lust for power, or an attempt to justify the injustices and cruelties committed by one group against groups of peoples judged inferior. The choice also stems from naive or willful ignorance of History, of the rises and falls of civilizations occasioned by Men, the environment, and circumstances. Peoples of Africa have experienced such ups and downs. Despite their current technological lagging behind peoples of other continents, Africans should not lose sight of their glorious history, of centuries passed when they commanded and inspired the whole of humanity. This recollection is the sine qua non prelude to Africa's renaissance.
A Knight of the Golden Circle
This work has been selected by scholars as being culturally important and is part of the knowledge base of civilization as we know it.This work is in the public domain in the United States of America, and possibly other nations. Within the United States, you may freely copy and distribute this work, as no entity (individual or corporate) has a copyright on the body of the work.Scholars believe, and we concur, that this work is important enough to be preserved, reproduced, and made generally available to the public. To ensure a quality reading experience, this work has been proofread and republished using a format that seamlessly blends the original graphical elements with text in an easy-to-read typeface.We appreciate your support of the preservation process, and thank you for being an important part of keeping this knowledge alive and relevant.
Influence of Heredity and Environment on Weaning and Post-weaning Weights in Beef Cattle
This work has been selected by scholars as being culturally important and is part of the knowledge base of civilization as we know it.This work is in the public domain in the United States of America, and possibly other nations. Within the United States, you may freely copy and distribute this work, as no entity (individual or corporate) has a copyright on the body of the work.Scholars believe, and we concur, that this work is important enough to be preserved, reproduced, and made generally available to the public. To ensure a quality reading experience, this work has been proofread and republished using a format that seamlessly blends the original graphical elements with text in an easy-to-read typeface.We appreciate your support of the preservation process, and thank you for being an important part of keeping this knowledge alive and relevant.
The Respiratory Function of the Blood; Pt 2
This work has been selected by scholars as being culturally important and is part of the knowledge base of civilization as we know it.This work is in the public domain in the United States of America, and possibly other nations. Within the United States, you may freely copy and distribute this work, as no entity (individual or corporate) has a copyright on the body of the work.Scholars believe, and we concur, that this work is important enough to be preserved, reproduced, and made generally available to the public. To ensure a quality reading experience, this work has been proofread and republished using a format that seamlessly blends the original graphical elements with text in an easy-to-read typeface.We appreciate your support of the preservation process, and thank you for being an important part of keeping this knowledge alive and relevant.
Functional Neuro-anatomy, Including an Atlas of the Brain Stem
This work has been selected by scholars as being culturally important and is part of the knowledge base of civilization as we know it.This work is in the public domain in the United States of America, and possibly other nations. Within the United States, you may freely copy and distribute this work, as no entity (individual or corporate) has a copyright on the body of the work.Scholars believe, and we concur, that this work is important enough to be preserved, reproduced, and made generally available to the public. To ensure a quality reading experience, this work has been proofread and republished using a format that seamlessly blends the original graphical elements with text in an easy-to-read typeface.We appreciate your support of the preservation process, and thank you for being an important part of keeping this knowledge alive and relevant.
Benign, Encapsulated Tumors in the Lateral Ventricles of the Brain
This work has been selected by scholars as being culturally important and is part of the knowledge base of civilization as we know it.This work is in the public domain in the United States of America, and possibly other nations. Within the United States, you may freely copy and distribute this work, as no entity (individual or corporate) has a copyright on the body of the work.Scholars believe, and we concur, that this work is important enough to be preserved, reproduced, and made generally available to the public. To ensure a quality reading experience, this work has been proofread and republished using a format that seamlessly blends the original graphical elements with text in an easy-to-read typeface.We appreciate your support of the preservation process, and thank you for being an important part of keeping this knowledge alive and relevant.
The Human Lung
This work has been selected by scholars as being culturally important and is part of the knowledge base of civilization as we know it.This work is in the public domain in the United States of America, and possibly other nations. Within the United States, you may freely copy and distribute this work, as no entity (individual or corporate) has a copyright on the body of the work.Scholars believe, and we concur, that this work is important enough to be preserved, reproduced, and made generally available to the public. To ensure a quality reading experience, this work has been proofread and republished using a format that seamlessly blends the original graphical elements with text in an easy-to-read typeface.We appreciate your support of the preservation process, and thank you for being an important part of keeping this knowledge alive and relevant.
Human Intercourse Test Item
This work has been selected by scholars as being culturally important and is part of the knowledge base of civilization as we know it.This work is in the public domain in the United States of America, and possibly other nations. Within the United States, you may freely copy and distribute this work, as no entity (individual or corporate) has a copyright on the body of the work.Scholars believe, and we concur, that this work is important enough to be preserved, reproduced, and made generally available to the public. To ensure a quality reading experience, this work has been proofread and republished using a format that seamlessly blends the original graphical elements with text in an easy-to-read typeface.We appreciate your support of the preservation process, and thank you for being an important part of keeping this knowledge alive and relevant.
Advanced Principles of Proteomics
The proteome is the complete set of proteins that are produced by a living organism or system. It is subject to modification due to changes in requirement and stresses that an organism undergoes. The study of proteins is under the discipline of proteomics. Protein detection with antibodies, antibody-free protein detection, hybrid technologies and high-throughput proteomic technologies are prominent methodologies that are used for the detection and analysis of proteins. The study of proteomics has aided in new drug-discovery and in the understanding of complex plant-insect interactions. This book is a compilation of chapters that discuss the most vital concepts and emerging trends in the field of proteomics. The various advancements are glanced at and their applications as well as ramifications are looked at in detail. The extensive content of this book provides the readers with a thorough understanding of the subject.
Understanding Biodiversity
The variability of life on earth is known as biodiversity. It is primarily concerned with the measurement of the variation at the genetic, species and ecosystem level. Important sub-fields of biodiversity include terrestrial biodiversity and marine biodiversity. Terrestrial biodiversity is found in the areas near the equator due to warm climate and high primary productivity. The diversity of all living beings is based on their habitat and factors such as temperature, altitude soils, geography, soils, and precipitation. The field known as biogeography is also related to the biodiversity. It is the study of the spatial distribution of organisms, species and ecosystems. This book is a compilation of chapters that discuss the most vital concepts in the field of biodiversity. Such selected concepts that redefine this field have been presented in this book. The topics covered in it offer the readers new insights in this field.
Essential Cell Biology
The branch of biology which deals with the study of the function and structure of the cell is referred to as cell biology. It focuses on the physiological attributes, metabolic processes and life cycle of the cell. It also studies the signaling pathways, chemical composition and interactions of the cell with their environment. It encompasses both prokaryotic and eukaryotic cells. Research in this field is conducted on both microscopic and molecular levels. The knowledge of the components of cells as well as their functioning plays a vital role in the studies related to different bio-medical fields. This textbook is a valuable compilation of topics, ranging from the basic to the most complex theories and principles in the field of cell biology. Some of the diverse topics covered herein address the varied branches that fall under this category. This book will provide comprehensive knowledge to the readers.
Marine Mammals: A Comprehensive Study
Marine mammals are the aquatic organisms that depend on the ocean and other marine ecosystems for their survival. Such organisms include sea otters, seals, manatees, whales and polar bears. The adaptation of marine mammals to an aquatic lifestyle varies from species to species. Some mammals such as cetaceans and sirenians are fully aquatic. Animals such as seals and sea lions are semiaquatic. They spend a major part of their life inside water but they need to come to land to perform some specific activities such as molting, breeding and mating. Some marine mammals such as polar bears and otters are much less adapted to an aquatic lifestyle. Marine mammals have numerous anatomical and physiological features which assist them in overcoming the challenges associated with aquatic living. The topics included in this textbook on marine mammals are of utmost significance and bound to provide incredible insights to readers. Also included herein is a detailed explanation of the various concepts and theories related to this subject. This book is an essential guide for both academicians and those who wish to pursue this discipline further.
Microbiology: An Integrated Approach
Microbiology is the study of microbial life. This discipline encompasses the study of acellular, unicellular and multicellular organisms, such as viruses, bacteria, archaea, fungi, algae, etc. The study of microbiology is significant due to the extensive use of microorganisms in industrial fermentation processes, bioremediation of wastes and for the production of a variety of biopolymers, such as polyesters, polysaccharides and polyamides. There is immense scope of microbial use in medical science, notable among which are antibiotic production, production of beneficial vitamins and amino acids, suppression of pathogenic microbes and development of biopolymers with applications in tissue engineering and drug delivery. Research that explores microbes as therapeutic agents against cancer is also being pursued. This book brings forth some of the most innovative concepts and elucidates the unexplored aspects of microbiology. The various advancements in this area of study are glanced at and their applications as well as ramifications are looked at in detail. With state-of-the-art inputs by acclaimed experts of this field, this book targets students and professionals.
Parasitology
The study of parasites and their hosts is referred to as parasitology. It also includes the study of the relationship between them. It is a biological field that draws on techniques from various fields such as bioinformatics, biochemistry, cell biology, genetics, ecology, immunology, molecular biology and evolution. Some of the branches of parasitology are medical parasitology, veterinary parasitology and structural parasitology. Medical parasitology deals with the parasites that infect humans and the diseases caused by them. It also focuses on various methods used to diagnose, prevent, control and treat such diseases. The study of parasites that leads to economic losses in agriculture and aquaculture operations infecting the companion animals fall under veterinary parasitology. This book explores all the important aspects of parasitology in the present day scenario. It aims to shed light on some of the unexplored aspects of this field. This book will serve as a valuable source of reference for those interested in this field.
Principles of Proteomics
The large-scale study of proteins is known as proteomics. A set of proteins that is produced and modified by an organism or system is named as proteome. Proteomics has led to the identification of a large number of proteins. It is involved in the discovery of proteomes from various levels of protein composition, structure and activities. Proteomics plays an important role in functional genomics as well. Some of the common methods used in this field are protein detection with antibodies and antibody-free protein detection. It is applied in numerous fields such as identifying potential drugs and for revealing complex plant-insect interactions. This textbook presents the complex subject of proteomics in the most comprehensible and easy to understand language. Some of the diverse topics covered herein address the varied branches that fall under this category. Through this book, we attempt to further enlighten the readers about the new concepts in this field.
Advanced Principles and Techniques in Tissue Engineering
Tissue engineering is a field that uses the principles of engineering, material methods and suitable biochemical and physiochemical factors in combination of cells to improve or replace biological tissues. It is related to applications that repair or replace whole tissues or a portion of tissues such as bone, cartilage, blood vessels, bladder and skin. It involves the use of a tissue scaffold for a medical purpose which helps in the formation of new viable tissue. It also uses living cells as engineering materials, for example in skin repair or replacement, it utilizes living fibroblasts, cartilage repaired with living chondrocytes, etc. It also aims to perform some biochemical functions using cells within an artificially-created support system such as the artificial pancreas or bio artificial liver. This book contains some path-breaking studies in the field of tissue engineering. It strives to provide a fair idea about this discipline and to help develop a better understanding of the latest advances within this field. This book is a resource guide for experts as well as students.
Textbook of Biotechnology
Biotechnology is a field of biology that makes use of living systems and organisms to develop products. It is a broad field that includes principles from the fields of genomics, immunology and recombinant genetics. It is also used in the development of pharmaceutical therapies and diagnostic tests. Some of the major branches of biotechnology are bioinformatics, green biotechnology, violet biotechnology and yellow biotechology. Green biotechnology refers to the application of the principles of biotechnology to agricultural processes. The issues of philosophy, law and ethics related to biotechnology are dealt with under the sub-domain of violet biotechnology. The utilization of biotechnology for the purpose of food production is referred to as yellow biotechnology. Major sectors in which biotechnology is applied are health care, food production and agriculture. This book provides comprehensive insights into the field of biotechnology. Most of the topics introduced in this book cover new techniques and the applications of this field. It will provide comprehensive knowledge to the readers.
Introduction to Proteomics
The scientific study of proteins is known as proteomics. Proteins perform various essential functions in living organisms. Proteomes are the sets of proteins that are modified and created by an organism. It is useful in identification of the increasing number of proteins. Proteomics utilizes the genetic information provided by various genome projects such as the human genome project. It explores the proteomes from several levels of protein composition, structure and activity. Proteomics is a vital component of functional genomics which attempts to explain the functions and interactions of genes. Some of the processes studied within this discipline are protein exploration, protein interactions, protein phosphorylation, etc. The topics included in this book on proteomics are of utmost significance and bound to provide incredible insights to readers. Such selected concepts that redefine this field have been presented herein. Through this book, we attempt to further enlighten the readers about the new concepts in this field.
Global Biodiversity and Ecological Conservation
The measure of biodiversity or the total variability of life forms on Earth is known as global biodiversity. Extinction and speciation have a substantial effect on global biodiversity. Besides these, some of the major drivers of change to biodiversity are habitat change, pollution, climate change, invasive species and overexploitation. Some of the categories of diversity are ecological, morphological, taxonomic and genetic diversity. Conservation biology is concerned with the study of the phenomena that affect the loss, maintenance and restoration of biodiversity. An understanding of indicator species, keystone species and umbrella and flagship species is vital to the study of biodiversity and its conservation. This book discusses the fundamentals as well as modern approaches of ecological conservation. It also provides comprehensive insights into global biodiversity. This book will serve as a resource guide for ecologists, environmentalists, conservation biologists, researchers, experts and students associated with this field.
Introduction to Developmental Biology
The study of the processes through which plants and animals grow and develop is referred to as developmental biology. It encompasses various areas of study such as biology of regeneration, metamorphosis, asexual reproduction as well as the growth of stem cells in the adult organisms. The developmental processes of organisms are divided into two major categories, namely, cell differentiation and regeneration. The process in which different functional cell types arise during development is known as cell differentiation. The ability to regrow a missing part is known as regeneration. Some of the other processes studied within this field are regional specification, morphogenesis and growth. This book unfolds the innovative aspects of developmental biology which will be crucial for the progress of this field in the future. The topics included herein on this subject are of utmost significance and bound to provide incredible insights to readers. Coherent flow of topics, student-friendly language and extensive use of examples make this book an invaluable source of knowledge.
Genetics: Concepts and Applied Principles
Genetics can be defined as the study of genes, inheritance of traits and variation in living organisms. It is an essential aspect of biology and provides insights into how evolution occurs. The inheritance of traits in genetics is understood with the tools of pedigree charts, Punnett squares and twin studies. The understanding of genes requires comprehension of gene expression, extra nuclear inheritance, mutation, epigenetics and control of development. Some of the modern focus areas of genetics are alternative splicing, mobile genetic elements, genomics, genetic engineering and horizontal gene transfer. The genetics of human behavior is another area of constant research. The genetic contribution to the development of schizophrenia, autism, ADHD and drug abuse are some of the conditions that are being actively investigated. This book includes some of the vital pieces of work being conducted across the world, on various topics related to genetics. It provides significant information of this discipline to help develop a good understanding of the concepts and applied principles of genetics.
Genetic Mapping and DNA Sequencing: Principles, Analysis and Applications
Proximate DNA sequences on a chromosome are inherited together during sexual reproduction. This tendency of DNA sequences is called genetic linkage. On a chromosome, the closer two genes are, the higher are their chances of being inherited together and lower are the chances of recombination between them. Gene mapping refers to the set of methods that allow the identification of the locus of a gene as well as the distances between genes. It offers evidences regarding the genes that are responsible for the inheritance of disease from parent to child, and also provides clues regarding the location of the genes and the chromosome where they are located. DNA sequencing is the process that determines the nucleic acid sequence or the order of nucleotides in the DNA. It encompasses all methods that can determine the order of the four bases- thymine, guanine, adenine and cytosine. The development of genetic maps and the successful sequencing of the human genome have advanced the frontiers of genetics and medical science. This book aims to shed light on some of the unexplored aspects of genetic mapping and DNA sequencing and the recent researches in these domains. It includes some of the vital pieces of work being conducted across the world, on various topics related to these fields. This book will prove immensely beneficial to geneticists, genetic engineers, students and researchers associated with these areas of study.
Fundamentals of Biochemistry
The study of chemical processes related to living organisms is referred to as biochemistry. It is a sub-field of both biology and chemistry. It is divided into fields like molecular genetics, protein science, and metabolism. Biochemistry focuses on how biological molecules give rise to processes that occur within and between the living cells. It also helps in the study and understanding of tissues and organs of an organism. Biochemistry focuses on the structures, functions, and interactions of biological macromolecules such as nucleic acids, carbohydrates, protein, and lipids. The topics included in this textbook on biochemistry are of utmost significance and bound to provide incredible insights to readers. Some of the diverse topics covered in this book address the varied branches that fall under this category. In this textbook, constant effort has been made to make the understanding of the difficult concepts of biochemistry as easy and informative as possible, for the readers.
DNA Repair: Mechanisms and Clinical Significance
The collection of processes required to identify and correct the damage in the DNA molecules is known as DNA repair. DNA damage can be caused by metabolic activities and environmental factors. Cells are not able to function properly if the integrity and accessibility of essential information gets corrupted by DNA damage. So, to restore the correct information, various strategies have been evolved according to the type of damage occurred in the double helical structure of DNA. Some of these mechanisms are single-strand damage, double-strand breaks, direct reversal, and translesion synthesis. In single strand damage, one of the two strands of the double helix has a defect and the other strand can be used as a template to correct the defect. This book aims to shed light on some of the unexplored aspects of DNA repair and the recent researches in this field. It traces the progress of this field and highlights some of its key concepts. This book will provide comprehensive knowledge to the readers.
Biofuels Production - Sustainability and Advances in Microbial Bioresources
This book focuses on the different kinds of biofuels and biofuel resources. Biofuels represent a major type of renewable energy. As part of a larger bio-economy, they are closely linked to agriculture, forestry and manufacturing. Biofuels have the potential to improve regional energy access, reduce dependence on fossil fuels and contribute to climate protection. Further, this alternative form of energy could revitalize the forestry and agricultural sector and promote the increased use of renewable resources as raw materials in a range of industrial processes. Efforts are continuously being made to develop economically competitive biofuels, and microbes play important roles in the production of biofuels from various bioresources. This book elaborates on recent advances in existing microbial technologies and on sustainable approaches to improving biofuel production processes. Additionally, it examines trends in, and the limitations of, existing processes and technologies. The book offers a comprehensive overview of microbial bioresources, microbial technologies, advances in bioconversion and biorefineries, as well as microbial and metabolic engineering for efficient biofuel production. Readers will also learn about the environmental impacts and the influence of climate change on the sustainability of biofuel production. This book is intended for researchers and students whose work involves biorefinery technologies, microbiology, biotechnology, agriculture, environmental biology and related fields.
Biophotonics, Tryptophan and Disease
Biophotonics, Tryptophan and Disease is a comprehensive resource on the key role of tryptophan in wide range of diseases as seen by using optics techniques. It explores the use of fluorescence spectroscopy, Raman, imaging techniques and time-resolved spectroscopy in normal and diseased tissues and shows the reader how light techniques (i.e. spectroscopy and imaging) can be used to detect, distinguish and evaluate diseases. Diseases covered include cancer, neurodegenerative diseases and other age-related diseases. Biophotonics, Tryptophan and Disease offers a clear presentation of techniques and integrates material from different disciplines into one resource. It is a valuable reference for students and interdisciplinary researchers working on the interface between biochemistry and molecular biology, translational medicine, and biophotonics.
The Anatomy of Work
This work has been selected by scholars as being culturally important and is part of the knowledge base of civilization as we know it.This work is in the public domain in the United States of America, and possibly other nations. Within the United States, you may freely copy and distribute this work, as no entity (individual or corporate) has a copyright on the body of the work.Scholars believe, and we concur, that this work is important enough to be preserved, reproduced, and made generally available to the public. To ensure a quality reading experience, this work has been proofread and republished using a format that seamlessly blends the original graphical elements with text in an easy-to-read typeface.We appreciate your support of the preservation process, and thank you for being an important part of keeping this knowledge alive and relevant.
An Anatomical Disquisition on the Motion of the Heart & Blood in Animals;
This work has been selected by scholars as being culturally important and is part of the knowledge base of civilization as we know it.This work is in the public domain in the United States of America, and possibly other nations. Within the United States, you may freely copy and distribute this work, as no entity (individual or corporate) has a copyright on the body of the work.Scholars believe, and we concur, that this work is important enough to be preserved, reproduced, and made generally available to the public. To ensure a quality reading experience, this work has been proofread and republished using a format that seamlessly blends the original graphical elements with text in an easy-to-read typeface.We appreciate your support of the preservation process, and thank you for being an important part of keeping this knowledge alive and relevant.
Evolution, Genetics, and Man
This work has been selected by scholars as being culturally important and is part of the knowledge base of civilization as we know it.This work is in the public domain in the United States of America, and possibly other nations. Within the United States, you may freely copy and distribute this work, as no entity (individual or corporate) has a copyright on the body of the work.Scholars believe, and we concur, that this work is important enough to be preserved, reproduced, and made generally available to the public. To ensure a quality reading experience, this work has been proofread and republished using a format that seamlessly blends the original graphical elements with text in an easy-to-read typeface.We appreciate your support of the preservation process, and thank you for being an important part of keeping this knowledge alive and relevant.
Life's Beginning on the Earth
This work has been selected by scholars as being culturally important and is part of the knowledge base of civilization as we know it.This work is in the public domain in the United States of America, and possibly other nations. Within the United States, you may freely copy and distribute this work, as no entity (individual or corporate) has a copyright on the body of the work.Scholars believe, and we concur, that this work is important enough to be preserved, reproduced, and made generally available to the public. To ensure a quality reading experience, this work has been proofread and republished using a format that seamlessly blends the original graphical elements with text in an easy-to-read typeface.We appreciate your support of the preservation process, and thank you for being an important part of keeping this knowledge alive and relevant.
An Introduction to the Genetics of Habrobracon Juglandis Ashmead
This work has been selected by scholars as being culturally important and is part of the knowledge base of civilization as we know it.This work is in the public domain in the United States of America, and possibly other nations. Within the United States, you may freely copy and distribute this work, as no entity (individual or corporate) has a copyright on the body of the work.Scholars believe, and we concur, that this work is important enough to be preserved, reproduced, and made generally available to the public. To ensure a quality reading experience, this work has been proofread and republished using a format that seamlessly blends the original graphical elements with text in an easy-to-read typeface.We appreciate your support of the preservation process, and thank you for being an important part of keeping this knowledge alive and relevant.
Explorer of the Human Brain
This work has been selected by scholars as being culturally important and is part of the knowledge base of civilization as we know it.This work is in the public domain in the United States of America, and possibly other nations. Within the United States, you may freely copy and distribute this work, as no entity (individual or corporate) has a copyright on the body of the work.Scholars believe, and we concur, that this work is important enough to be preserved, reproduced, and made generally available to the public. To ensure a quality reading experience, this work has been proofread and republished using a format that seamlessly blends the original graphical elements with text in an easy-to-read typeface.We appreciate your support of the preservation process, and thank you for being an important part of keeping this knowledge alive and relevant.
Medical Laboratory Methods and Tests [microform]
This work has been selected by scholars as being culturally important and is part of the knowledge base of civilization as we know it.This work is in the public domain in the United States of America, and possibly other nations. Within the United States, you may freely copy and distribute this work, as no entity (individual or corporate) has a copyright on the body of the work.Scholars believe, and we concur, that this work is important enough to be preserved, reproduced, and made generally available to the public. To ensure a quality reading experience, this work has been proofread and republished using a format that seamlessly blends the original graphical elements with text in an easy-to-read typeface.We appreciate your support of the preservation process, and thank you for being an important part of keeping this knowledge alive and relevant.
The Adrenals
This work has been selected by scholars as being culturally important and is part of the knowledge base of civilization as we know it.This work is in the public domain in the United States of America, and possibly other nations. Within the United States, you may freely copy and distribute this work, as no entity (individual or corporate) has a copyright on the body of the work.Scholars believe, and we concur, that this work is important enough to be preserved, reproduced, and made generally available to the public. To ensure a quality reading experience, this work has been proofread and republished using a format that seamlessly blends the original graphical elements with text in an easy-to-read typeface.We appreciate your support of the preservation process, and thank you for being an important part of keeping this knowledge alive and relevant.
The Rhabdocline Needle Cast of Douglas Fir
This work has been selected by scholars as being culturally important and is part of the knowledge base of civilization as we know it.This work is in the public domain in the United States of America, and possibly other nations. Within the United States, you may freely copy and distribute this work, as no entity (individual or corporate) has a copyright on the body of the work.Scholars believe, and we concur, that this work is important enough to be preserved, reproduced, and made generally available to the public. To ensure a quality reading experience, this work has been proofread and republished using a format that seamlessly blends the original graphical elements with text in an easy-to-read typeface.We appreciate your support of the preservation process, and thank you for being an important part of keeping this knowledge alive and relevant.
Egg Maturation, Chromosomes, and Spermatogenesis in Cyclops [microform]
This work has been selected by scholars as being culturally important and is part of the knowledge base of civilization as we know it.This work is in the public domain in the United States of America, and possibly other nations. Within the United States, you may freely copy and distribute this work, as no entity (individual or corporate) has a copyright on the body of the work.Scholars believe, and we concur, that this work is important enough to be preserved, reproduced, and made generally available to the public. To ensure a quality reading experience, this work has been proofread and republished using a format that seamlessly blends the original graphical elements with text in an easy-to-read typeface.We appreciate your support of the preservation process, and thank you for being an important part of keeping this knowledge alive and relevant.
The Evolution of Development; Three Special Lectures Given at University College, London
This work has been selected by scholars as being culturally important and is part of the knowledge base of civilization as we know it.This work is in the public domain in the United States of America, and possibly other nations. Within the United States, you may freely copy and distribute this work, as no entity (individual or corporate) has a copyright on the body of the work.Scholars believe, and we concur, that this work is important enough to be preserved, reproduced, and made generally available to the public. To ensure a quality reading experience, this work has been proofread and republished using a format that seamlessly blends the original graphical elements with text in an easy-to-read typeface.We appreciate your support of the preservation process, and thank you for being an important part of keeping this knowledge alive and relevant.
The Anatomy of Tarsius Spectrum
This work has been selected by scholars as being culturally important and is part of the knowledge base of civilization as we know it.This work is in the public domain in the United States of America, and possibly other nations. Within the United States, you may freely copy and distribute this work, as no entity (individual or corporate) has a copyright on the body of the work.Scholars believe, and we concur, that this work is important enough to be preserved, reproduced, and made generally available to the public. To ensure a quality reading experience, this work has been proofread and republished using a format that seamlessly blends the original graphical elements with text in an easy-to-read typeface.We appreciate your support of the preservation process, and thank you for being an important part of keeping this knowledge alive and relevant.
Health Lessons,
This work has been selected by scholars as being culturally important and is part of the knowledge base of civilization as we know it.This work is in the public domain in the United States of America, and possibly other nations. Within the United States, you may freely copy and distribute this work, as no entity (individual or corporate) has a copyright on the body of the work.Scholars believe, and we concur, that this work is important enough to be preserved, reproduced, and made generally available to the public. To ensure a quality reading experience, this work has been proofread and republished using a format that seamlessly blends the original graphical elements with text in an easy-to-read typeface.We appreciate your support of the preservation process, and thank you for being an important part of keeping this knowledge alive and relevant.
Memorial Papers; 2
This work has been selected by scholars as being culturally important and is part of the knowledge base of civilization as we know it.This work is in the public domain in the United States of America, and possibly other nations. Within the United States, you may freely copy and distribute this work, as no entity (individual or corporate) has a copyright on the body of the work.Scholars believe, and we concur, that this work is important enough to be preserved, reproduced, and made generally available to the public. To ensure a quality reading experience, this work has been proofread and republished using a format that seamlessly blends the original graphical elements with text in an easy-to-read typeface.We appreciate your support of the preservation process, and thank you for being an important part of keeping this knowledge alive and relevant.
Biophysics
This work has been selected by scholars as being culturally important and is part of the knowledge base of civilization as we know it.This work is in the public domain in the United States of America, and possibly other nations. Within the United States, you may freely copy and distribute this work, as no entity (individual or corporate) has a copyright on the body of the work.Scholars believe, and we concur, that this work is important enough to be preserved, reproduced, and made generally available to the public. To ensure a quality reading experience, this work has been proofread and republished using a format that seamlessly blends the original graphical elements with text in an easy-to-read typeface.We appreciate your support of the preservation process, and thank you for being an important part of keeping this knowledge alive and relevant.
The Part Played by Labour in the Transition From Ape to Man
This work has been selected by scholars as being culturally important and is part of the knowledge base of civilization as we know it.This work is in the public domain in the United States of America, and possibly other nations. Within the United States, you may freely copy and distribute this work, as no entity (individual or corporate) has a copyright on the body of the work.Scholars believe, and we concur, that this work is important enough to be preserved, reproduced, and made generally available to the public. To ensure a quality reading experience, this work has been proofread and republished using a format that seamlessly blends the original graphical elements with text in an easy-to-read typeface.We appreciate your support of the preservation process, and thank you for being an important part of keeping this knowledge alive and relevant.
Memorial Papers; 1
This work has been selected by scholars as being culturally important and is part of the knowledge base of civilization as we know it.This work is in the public domain in the United States of America, and possibly other nations. Within the United States, you may freely copy and distribute this work, as no entity (individual or corporate) has a copyright on the body of the work.Scholars believe, and we concur, that this work is important enough to be preserved, reproduced, and made generally available to the public. To ensure a quality reading experience, this work has been proofread and republished using a format that seamlessly blends the original graphical elements with text in an easy-to-read typeface.We appreciate your support of the preservation process, and thank you for being an important part of keeping this knowledge alive and relevant.
Man, Microbe, and Malady
This work has been selected by scholars as being culturally important and is part of the knowledge base of civilization as we know it.This work is in the public domain in the United States of America, and possibly other nations. Within the United States, you may freely copy and distribute this work, as no entity (individual or corporate) has a copyright on the body of the work.Scholars believe, and we concur, that this work is important enough to be preserved, reproduced, and made generally available to the public. To ensure a quality reading experience, this work has been proofread and republished using a format that seamlessly blends the original graphical elements with text in an easy-to-read typeface.We appreciate your support of the preservation process, and thank you for being an important part of keeping this knowledge alive and relevant.

![Medical Laboratory Methods and Tests [microform] Medical Laboratory Methods and Tests [microform]](https://cdn.kingstone.com.tw/english/images/product/0014/9781013750014.jpg)


![Egg Maturation, Chromosomes, and Spermatogenesis in Cyclops [microform] Egg Maturation, Chromosomes, and Spermatogenesis in Cyclops [microform]](https://cdn.kingstone.com.tw/english/images/product/3410/9781014993410.jpg)







